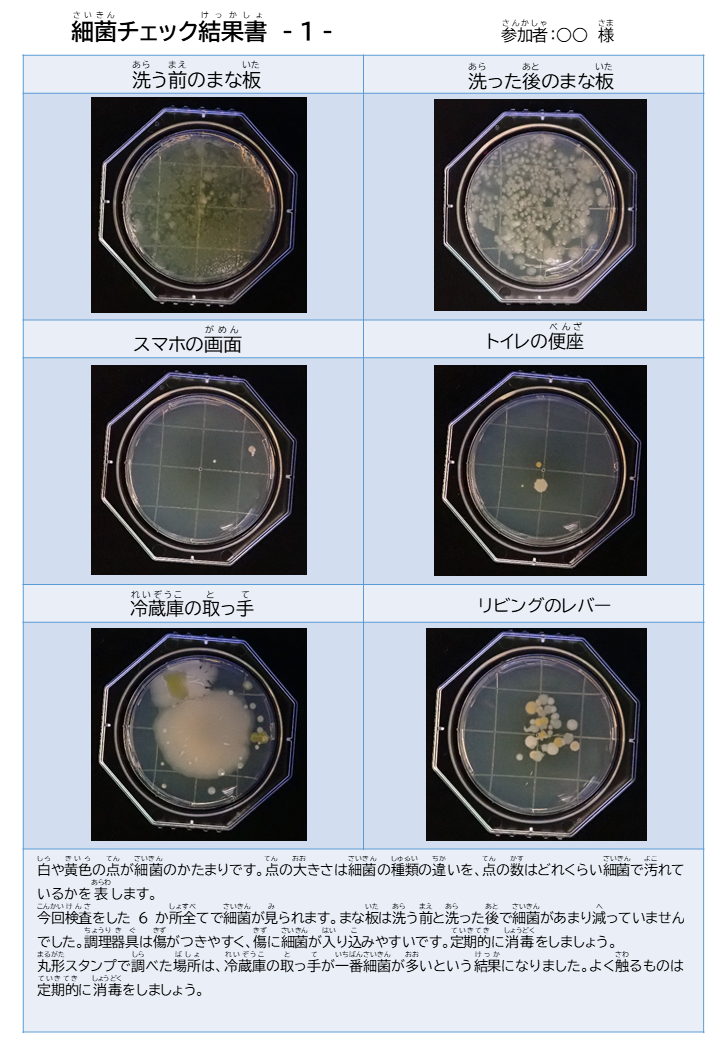
結果書１
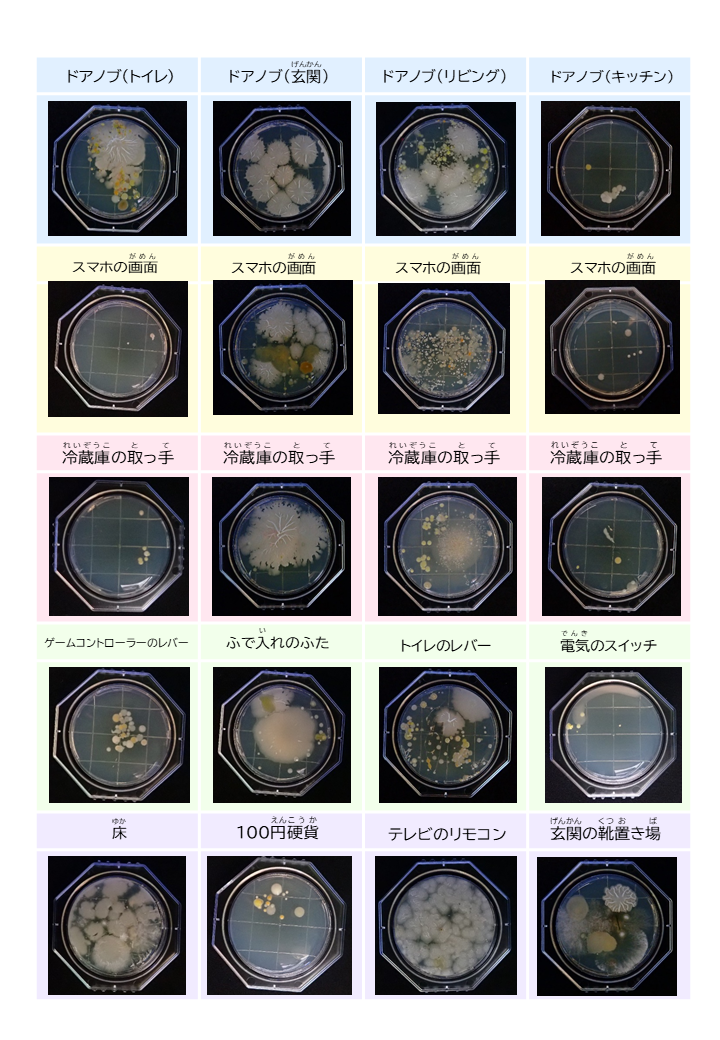
丸形スタンプ結果

【実施報告】
「令和4年度 食の安全塾~目で見て分かるぺったん検査~
お家でできる衛生チェック」
今年度の食の安全塾は、手洗いの大切さや食品衛生に関する知識を学んでいただくことを目的として、
福岡市内在住の小学生と保護者の方を対象に実施しました。
参加者のみなさんにテキストと細菌チェックセットを郵送して、
自宅の検査を行っていただきました。



参加者の手洗い前後の手指と、家庭で気になる所に細菌チェックセットでぺったん検査してもらいました。


自宅で検査した細菌チェックセットを返送してもらい、保健所で細菌を増やして、見えるようにしました。
増やした結果を結果書にまとめ、ひとりひとりにお返ししました。
丸い点が細菌です。

参加者のみなさんがさまざまな場所を検査してくださいました!
手洗い前後の結果を手洗いにかけた時間別に比べました!

参加者からは
「子どもの手洗いが全然上手にできていないことに驚いた。」
「とてもおもしろい内容でよかった。」
「もう一度同じ内容でやってみたい。」
といった声をいただきました。
参加者のみなさまありがとうございました。
食の安全をテーマにした「みて、きいて、安心!食の安全塾」は今後も開催予定です。
みなさまの参加をお待ちしています!



 東区
東区 博多区
博多区 中央区
中央区 南区
南区 城南区
城南区 早良区
早良区 西区
西区